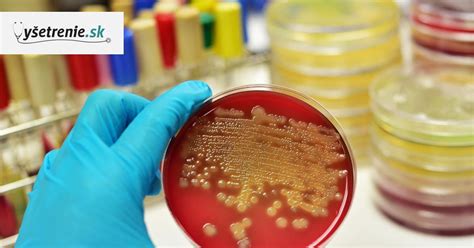
Ilustrácia baktérií odolných voči antibiotikám

Vysoké hodnoty C-reaktívneho proteínu (CRP) v krvi sú často prvým signálom, že organizmus bojuje so zápalom alebo infekciou. CRP je bielkovina produkovaná pečeňou ako súčasť imunitnej odpovede. Jeho hladina v krvi stúpa pri akútnej fáze zápalu, pričom rýchlosť a miera zvýšenia môžu naznačovať charakter a závažnosť problému. Vďaka rýchlemu a bezbolestnému CRP testu, ktorý sa dá vykonať z malej kvapky krvi z prsta, dokážu lekári pomerne presne odhadnúť, či ide o vírusovú alebo bakteriálnu infekciu. Toto rozlíšenie je kľúčové, pretože antibiotiká sú účinné len proti baktériám, zatiaľ čo pri vírusových infekciách (virózach) sú neúčinné a ich užívanie je zbytočné a potenciálne škodlivé.

CRP ako ukazovateľ zápalu a infekcie
CRP, teda C-reaktívny proteín, je označenie pre bielkovinu, ktorú telo vytvára pri zápale alebo infekcii. Je to jeden z takzvaných akútnych fázových proteínov, čo znamená, že jeho hladina v krvi sa dokáže pomerne rýchlo zvýšiť už niekoľko hodín po vzniku zápalového procesu. Tento proteín je súčasťou vrodenej imunity a jeho hlavnou funkciou je aktivovať komplementový systém a pomáhať pri odstraňovaní patogénov. Hladina CRP v krvi stúpa hlavne pri bakteriálnej infekcii, zatiaľ čo pri bežnej viróze býva väčšinou nižšia alebo len mierne zvýšená.
Normálna hodnota CRP u zdravého človeka sa obvykle pohybuje do 5 mg/l. Aj keď tieto hodnoty môžu mierne kolísať, významnejšie zvýšenie signalizuje, že v tele prebieha zápalová reakcia. Preto je CRP test tak cenným nástrojom v diagnostike. Pomáha lekárom rýchlo získať informáciu o tom, či je potrebná intenzívnejšia liečba, ako napríklad antibiotiká, alebo či si stav nevyžaduje špecifickú liečbu a postačí len symptomatická alebo podporná terapia.
Rozlišovanie medzi vírusovou a bakteriálnou infekciou pomocou CRP
Správne určenie pôvodcu infekcie je kľúčové pre efektívnu liečbu a predchádzanie komplikáciám, ako je napríklad antibiotická rezistencia. Bežné príznaky ako nádcha, kašeľ, bolesť v krku alebo horúčka sa môžu objavovať pri vírusových aj bakteriálnych ochoreniach. V takýchto prípadoch, kde je klinické vyšetrenie často nedostatočné na jednoznačné rozlíšenie, prichádza na rad CRP test.
Nízke hodnoty CRP (zvyčajne do 10 mg/l) často ukazujú na vírusovú infekciu, napríklad bežné prechladnutie, chrípku alebo aj niektoré miernejšie formy infekcií močových ciest. Pri týchto vírusových ochoreniach antibiotiká nepomáhajú a ich užívanie nemá zmysel. Naopak, mierne zvýšené hodnoty CRP (napríklad 6 až 30 mg/l) môžu naznačovať miernu infekciu, ktorá môže byť stále vírusového pôvodu, ale aj začínajúcu bakteriálnu infekciu. V takýchto hraničných prípadoch je často potrebné sledovať vývoj stavu a CRP test zopakovať o 1 až 2 dni.
Výraznejšie zvýšené hodnoty CRP, najmä nad 30-40 mg/l, zvyšujú podozrenie na bakteriálnu infekciu. V prípade infekcií močových ciest, ak je podozrenie na bakteriálny pôvod, lekár môže na základe vysokých hodnôt CRP a ďalších klinických príznakov indikovať nasadenie antibiotík. Je dôležité si uvedomiť, že CRP je len indikátorom zápalu a nenahrádza komplexné lekárske vyšetrenie. Interpretácia hodnôt CRP vždy patrí do rúk lekára, ktorý zohľadňuje aj celkový stav pacienta, jeho symptómy a výsledky iných vyšetrení.

Nízke CRP a infekcie močových ciest: Kedy sa netreba obávať?
Infekcie močových ciest (IMČ) sú častým zdravotným problémom, ktorý postihuje najmä ženy. Príznaky ako pálenie pri močení, časté nutkanie na močenie, bolesť v podbrušku alebo v oblasti krížov sú typické. V mnohých prípadoch môžu byť IMČ spôsobené vírusmi alebo inými patogénmi, ktoré si organizmus dokáže zvládnuť sám, alebo si vyžadujú liečbu, ktorá nie je založená na antibiotikách.
Ak má pacient pri podozrení na infekciu močových ciest nízku hodnotu CRP (napríklad do 5 mg/l, alebo len mierne zvýšenú do 10 mg/l), často to naznačuje, že ide o menej závažný stav, pravdepodobne vírusového pôvodu, alebo o veľmi skoré štádium infekcie, kde imunitný systém ešte plne nereagoval zvýšenou produkciou CRP. V takýchto situáciách, ak nie sú prítomné silné príznaky, vysoké horúčky alebo iné varovné signály, lekár nemusí indikovať antibiotickú liečbu. Namiesto toho môže odporučiť dostatočný pitný režim, oddych a prípadne symptomatickú liečbu na zmiernenie nepríjemných príznakov.
Je však dôležité vedieť, že CRP môže byť na začiatku infekcie ešte nízke, pretože jeho hladina v krvi stúpa postupne. Preto, ak príznaky pretrvávajú alebo sa zhoršujú, aj pri počiatočnom nízkom CRP, je vhodné vyhľadať lekára a zvážiť opakovanie testu alebo ďalšie diagnostické metódy, ako je napríklad vyšetrenie moču.
CRP testy: Od laboratória po domáce použitie
CRP testy sú dnes široko dostupné a umožňujú rýchlu orientáciu v zdravotnom stave. Okrem klasických laboratórnych vyšetrení, kde sa odoberá krv zo žily, existujú aj moderné prístroje, ktoré umožňujú rýchle a presné vyšetrenie CRP (CRP+Hb) z malej kvapky krvi z prsta. Tieto prístroje dokážu výsledok poskytnúť do niekoľkých minút.
Domáci test CRP krok za krokom
V lekárňach sú tiež dostupné domáce CRP testy vo forme samodiagnostických súprav. Tieto testy, ktoré si pacient môže urobiť sám v pohodlí domova, sú rovnako založené na kvapke krvi z prsta a výsledok je známy do niekoľkých minút. Aj keď domáci CRP test môže pomôcť s orientáciou, v niektorých situáciách je lepšie vyhľadať lekára. Pozornosť by ste mali spozornieť najmä pri vysokej horúčke, silnej bolesti, ťažkostiach s dýchaním alebo rýchlom zhoršení stavu. K lekárovi je vhodné ísť aj vtedy, keď príznaky prechladnutia alebo infekcie dýchacích ciest trvajú niekoľko dní a nelepšia sa.
CRP testy na profesionálne využitie, ktoré sú presnejšie a často sa používajú v ambulanciách lekárov, poskytujú kvantitatívny výsledok v mg/l. Výsledky CRP testov v lekárni slúžia ako rýchla orientácia, či navštíviť lekára, alebo postačí domáca liečba a oddych. Je však dôležité si uvedomiť, že CRP test v lekárni nenahrádza lekársku diagnózu ani liečbu predpísanú lekárom.
Hranice hodnôt CRP a ich interpretácia
Interpretácia hodnôt CRP by mala byť vždy vykonávaná lekárom v kontexte s celkovým klinickým obrazom pacienta. Vo všeobecnosti však platí nasledujúce rozdelenie:
- Do 5 mg/l: Normálne hodnoty. Naznačujú, že v tele nie je prítomný žiadny zápal.
- 5 až 10 mg/l: Mierne zvýšené hodnoty. Môžu naznačovať mierny zápal, ktorý môže byť vírusového pôvodu, alebo drobné poškodenie tkaniva. V niektorých prípadoch môžu byť prítomné aj pri fyzickej záťaži, fajčení alebo chronických ochoreniach.
- 10 až 40 mg/l: Hraničné pásmo. V tomto intervale nie je vždy možné jednoznačne určiť pôvod infekcie len na základe CRP. Môže ísť o miernu infekciu, často vírusového pôvodu, ale aj o začínajúcu bakteriálnu infekciu. Pri pretrvávajúcich príznakoch je vhodné test zopakovať.
- 30 až 100 mg/l: Zvýšené hodnoty. Väčšinou naznačujú výraznejší zápal, ktorý môže byť bakteriálneho pôvodu. V prípade infekcií močových ciest by tieto hodnoty mohli viesť k zváženiu antibiotickej liečby.
- Nad 100 mg/l: Vysoké hodnoty. Signalizujú závažný zápalový proces, často spojený s akútnou bakteriálnou infekciou, ako je zápal pľúc, sepsa alebo iné ťažké infekcie. V takýchto prípadoch je antibiotická liečba často nevyhnutná a je potrebné konať okamžite.
Je dôležité si uvedomiť, že tieto hodnoty sú orientačné a môžu sa líšiť v závislosti od laboratória a použitej metódy. Niektoré faktory, ako napríklad užívanie určitých liekov (ibuprofén, aspirín), chronické ochorenia, alebo dokonca aj konzumácia alkoholu či kávy, môžu ovplyvniť výsledky CRP testu. Preto je vždy dôležité informovať lekára o všetkých užívaných liekoch a zdravotných problémoch.
Antibiotická rezistencia a zodpovedné užívanie antibiotík
Jedným z najväčších problémov modernej medicíny je rastúca antibiotická rezistencia. Nesprávne a nadmerné užívanie antibiotík, najmä pri vírusových infekciách, vedie k tomu, že baktérie si vyvíjajú odolnosť voči týmto liekom. Tým sa znižuje ich účinnosť a liečba vážnych bakteriálnych infekcií sa stáva čoraz náročnejšou.
CRP testy zohrávajú kľúčovú úlohu v zodpovednom používaní antibiotík. Pomáhajú lekárom odlíšiť, či ide o vírusovú infekciu, kde antibiotiká nie sú potrebné, alebo o bakteriálnu infekciu, kde môžu byť životne dôležité. Vďaka rýchlej diagnostike a presnému určeniu pôvodcu infekcie sa znižuje riziko zbytočného predpisovania antibiotík.
Farmaceuti tiež zohrávajú dôležitú úlohu v edukácii pacientov o správnom užívaní antibiotík a o rizikách antibiotickej rezistencie. Je nevyhnutné, aby pacienti užívali antibiotiká len na lekársky predpis, dodržiavali presné dávkovanie a dĺžku liečby, a nikdy si antibiotiká nenasadzovali sami bez konzultácie s lekárom.
Sledovanie liečby a pokles CRP
CRP testy sú užitočné nielen pri diagnostike, ale aj pri monitorovaní priebehu liečby. Po nasadení účinnej liečby, či už antibiotickej pri bakteriálnej infekcii, alebo symptomatickej pri vírusovej, by mala hladina CRP postupne klesať. Približne o 3 až 4 dni po nasadení liečby by mal byť viditeľný prvý pokles. Normálne hodnoty CRP sa potom zvyčajne upravia po 2 až 4 týždňoch, v závislosti od závažnosti pôvodnej infekcie.
Ak CRP hodnoty po nasadení liečby neklesajú alebo dokonca stúpajú, môže to signalizovať neúspešnú liečbu, komplikovaný priebeh ochorenia, alebo dokonca rozvoj rezistencie. V takýchto prípadoch lekár zvyčajne zopakuje vyšetrenia a zváži zmenu liečebného postupu. Rýchly pokles CRP po ústupe zápalového procesu je preto dobrým prognostickým znakom a potvrdením, že liečba je účinná.
V konečnom dôsledku, nízke CRP pri infekciách močových ciest alebo iných ochoreniach nie je vždy dôvodom na paniku, ale skôr informáciou, ktorá pomáha lekárovi pri správnom diagnostickom a terapeutickom rozhodovaní. Pochopenie významu CRP a jeho hodnôt v kontexte s ostatnými príznakmi a vyšetreniami umožňuje cielenejšiu a efektívnejšiu liečbu.